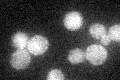
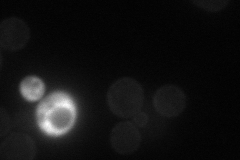
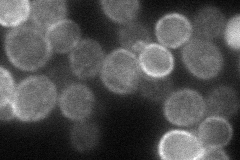

View description
Phosphatidylinositol-4-phosphate 5-kinase, involved in actin cytoskeleton organization and cell morphogenesis; multicopy suppressor of stt4 mutation
Localization:
Intensity:
Fold change:
Significance:
-
C’ GFP library in SD
cytosol26.7 -
N' NOP1pr-GFP in SD
cell periphery36.5221 -
N' TEF2pr-mCherry in SD
cell periphery83.8164 -
N' NATIVEpr-GFP in SD

below threshold23.0157 -
N' TEF2pr-VC and Cyto-VN in SD

cytosol29.6784 -
C’ GFP library in SD+DTT

cytosol24.760.92No -
C’ GFP library in SD+H2O2

cytosol21.450.8No -
C’ GFP library in Starvation Media

cytosol19.210.71No -
C’ GFP library on the background of Pup2-DaMP

cytosol -
C’ GFP library on the background of CCT mutant

cytosol28.79651.07827No
